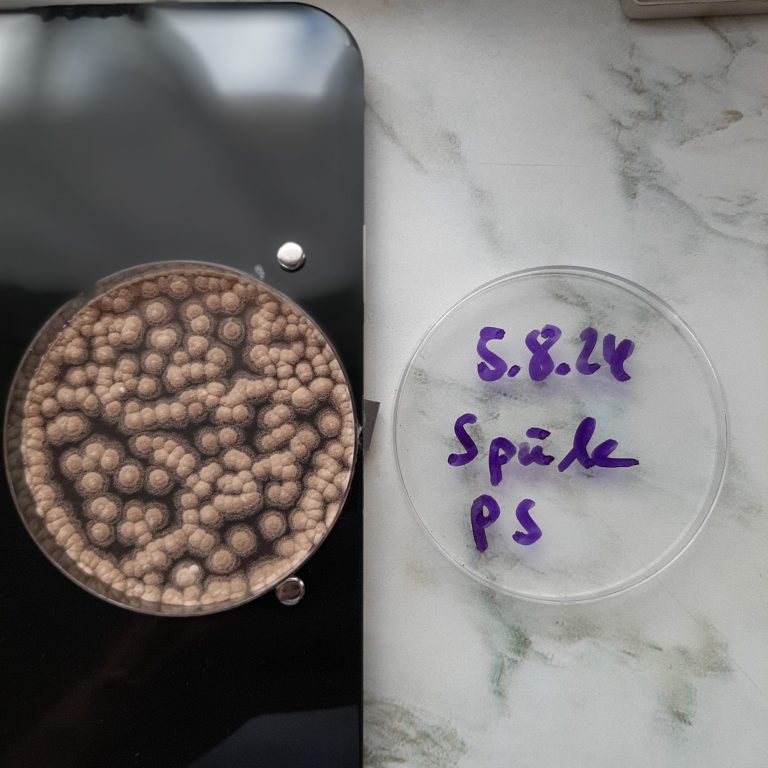
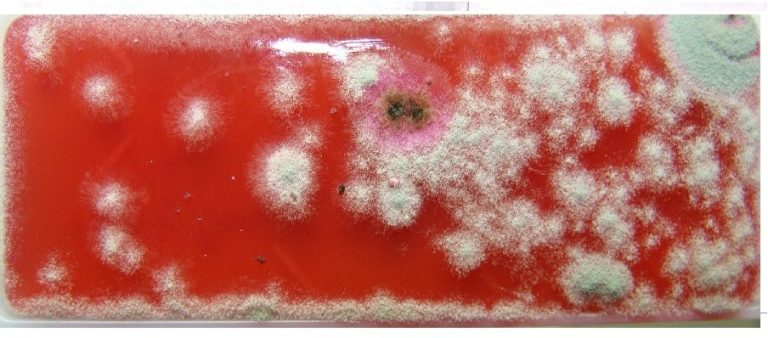
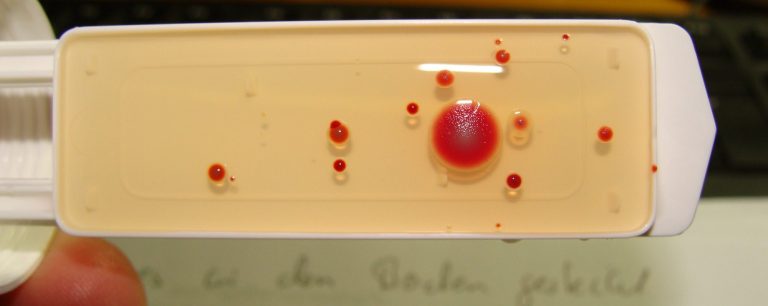

AKTUELLES

Für unsere Bauherren aus dem Bereich Bauwesen, suchen wir Aushilfen,
Bürohilfe (m/w),
Bauzeichner (m/w) / Bautechniker (m/w) / Konstrukteur (m/w),
Maurer,
Stahlbetonbauer,
Zimmerer,
Elektriker (m/w),
Heizungsbauer,
Bauhelfer sowie
Trockenbauer
- Sie sind körperlich fit und gesund?
- Sie beherrschen die deutsche Sprache soweit, dass Sie Anweisungen verstehen und sich selbst auch auf Deutsch verständlich machen können?
Dann sollten Sie sich bei uns schriftlich bewerben.
Einarbeitung erfolgt direkt vor Ort.
DESSAU-ROßLAU
Die Nachbarn: "Er war im Wasser"

Bild vom Wasserzähler mit Funktechnologie.
DIE NACHBARN: "GOOGLE IST KRANK"
Strom ist lebensgefährlich. Armaturen können Strom leiten. Falls Sie auch einen Schlag spüren, berühren Sie die Wannenarmatur nicht mehr.
DIE NACHBARN: "SIE BLÄST"

Bild von einer Ergas-Zentralheizung aus dem Keller.

Bild vom offenen Kamin aus dem Keller.
Die Heizung verbrennt Erdgas [Methan (CH4), Stickstoff (N2), Kohlendioxid (CO2), Schwefelwasserstoff (H2S) und Wasserdampf] mit Sauerstoff (O2) zu Kohlendioxid (CO2), Wasserdampf (H2O), Sickoxide (NOx) und Kohlenmonoxid (CO). Eine Erdgasheizung darf im Betrieb nicht riechen. Eine undichte Erdgasheizung kann Atemnot auslösen. Abgasgeruch in der Wohnung: Hinweis auf undichte Rohre.
Die Dachsanierung in Verbindung mit dem Rückbau eines alten Kamins ist eine sinnvolle Maßnahme, um Dachundichtigkeiten zu beheben und Platz zu schaffen. Eine Erdgasheizung im Keller produziert Abwärme in Form von heißen Verbrennungsgasen. Warme Luft steigt nach oben. Der Kamineffekt beschreibt das Phänomen, bei dem warme Luft in einem Kamin nach oben steigt und frische Luft strömt von unten nach. Ein stillgelegter, offener Schornstein kann durch die aufsteigende warme Abluft einer Heizung gefährliche Heizungsabgase und Flugasche aus dem Schornsteinfuß im Keller in die Wohnung drücken. Entferne die Flugasche und verschließe die Schonsteinöffnung mit Ziegeln und Mörtel.
"SIE WAREN IM BODEN"

Bild vom Boden: Die alukaschierte Trittschalldämmung

Bild vom Laminatboden
Grüne, alukaschierte Trittschalldämmplatten (häufig XPS = Extrudiertes Polystyrol-Hartschaumplatten) sind Unterlagen für schwimmend verlegte Laminatböden.
Sie bieten hohe Druckstabilität (für Klick-Verbindungen), verbesserte Trittschalldämmung und einen Feuchteschutz durch die Aluminiumschicht. Die Aluminiumschicht wirkt als Dampfsperre, um Feuchtigkeit vom Bodenbelag fernzuhalten.
Das grüne Pulver unter dem Laminat ist eine alte, zerbröselter, grüne Trittschalldämmplatte, die mit der Zeit zu feinem Pulver zerfallen ist.
XPS zerfällt im verbauten Zustand nicht und hält über 100 Jahre. Diese Platten sind grün eingefärbt und neigen bei Reibung zu zerbröseln, wodurch ein feines, grünes Kunstoffpulver entsteht.
Ältere XPS-Platen können durch Ausgasungen (z. B. Flammenschutzmittel oder Treibmittel) füchtige organische Verbindungen (VOC) abgeben. Wenn der chemische Gestank stechend bleibt oder Kopfschmerzen verursacht, solltest du die XPS-Dämmung ausbauen.
Das Pulver darf niemals mit Druckluft abgeblasen, trocken gekehrt werden, um Aufwirbelungen zu vermeiden, da dies die Partikel stundenlang in der Luft hält.
Wenn das Pulver aufgewirbelt und eingeatmet wird, führt es bei hoher Belastung zu Luftnot und Engegefühl in der Brust. Besonders kleine Partikel dringen tief bis in die Lunge vor und lösen dort Entzündungen aus. Gelten aber als ungiftig.
Sofortmaßnahmen bei Luftnot:
- Frische Luft: Den staubigen Bereich sofort verlassen und für Frischluft sorgen.
- Wenn die Luftnot von Brustschmerzen und starkem Husten begleitet wird, sollte sofort der Notruf gewählt werden.
Sorgen Sie während und nach der Arbeit für eine gründliche Durchlüftung der Räume.
Tragen Sie beim Reinigen eine Schutzausrüstung (Persönliche Kleidung, Staubschutzbrille, FFP2-Staubmaske und Schutzhandschuhe).
Die Reinigung erfolgt durch feuchtes Abwischen oder Absaugen mit einem Industriestaubsauger der über einen geeigneten Feinstaubfilter verfügt. Nutzen Sie feuchtes Abwischen und Industriestaubsauger, um Stäube sicher von Kleidung zu entfernen.
Laubbläser im Garten oder Hof werden häufig genutzt, um Split gegen Glätte von den Flächen zu pusten. Die Nutzung ist nicht verboten, solange Sie die gesetzlichen Ruhezeiten und Maschinenlärmschutzverordnung einhalten, da diese Geräte laut sind.
Die Polizei: "Sie sind angezeit wegen Körperverletzung. Dürfen wir reinkommen"
Ohne einem richterlichen Durchsuchungsbeschluss kommen Sie hier nicht rein.
"DIE HABEN HUSTEN"

Bild vom Ausrutscher: Der Totholzleger ist auf dem Friedhof.

Bild vom Totholz.
"DU BRÜHST SIE AB"
Bild vom Warmwasserspeicher: Das Chlor wird nicht in den Speicher geworfen. Die Zugabe erfolgt flüssig über eine Dosierpumpe.
Chlor ist zur Desinfektion im Warmwasserspeicher erlaubt. Es wird meist zur Stoßbehandlungen gegen Legionellen eingesetzt.
In hohen Konzentrationen reizt Chlor Haut, Augen und Atemwege. Es trocknet die Nasenwege aus und macht sie anfälliger für Viren oder Bakterien. Chlor kann die Schleimhäute reizen und eine Entzündung der Stirnhöhlen begünstigen und zu Atemnot führen als auch Textilien schaden.
"HOL ÖL"
Es entzieht der Haut natürliche Fette, was zu Trockenheit oder Ekzemen führen kann.
Im Leitungswasser deutet Chlorgeruch meist auf eine kurzfristige Desinfektion hin, oft nach Bauarbeiten. Es kann durch abkochen in einer Wasserleitung entfernt werden.
Das Wasserwerk: "Uns liegen keine Hinweise vor, dass zu diesen Zeitpunkt eine Chlorzugabe erfolgt ist"
Chlorrückstände können in Leitungen vorkommen. Wasserwerke fügen Chlor oft zur Desinfektion hinzu, besonders nach Rohrbrüchen.
"DAS ROHR IST KAPUTT"
Kanalgase wie Schwefelwasserstoff (H2S) verdrängen in hohen Konzentrationen den Sauerstoff und wirken toxisch auf das Nervensystem, was zu Atemnot führt.

Bild vom abgedichtetem Abflussrohr im Keller

Bild vom Abflussrohr mit Reinigungsöffnung

Bild vom Abflussrohr im Bad
Wenn ein Abflussrohr durch eine Holzbalkendecke führt, muss der Deckendurchbruch abgedichtet sein.
Wenn in einem Holzkasen verbautes Abflussrohr von der Nachbarin Frau Kopprasch undicht ist und Kanalgase in ihre Wohnung drückt, liegt eine akute Gefahr vor.
Die Polizei: "Das müssen Sie mit ihrem Vermieter klären"
Bei Gase aus der Nachbarwohnung sofort den Nachbarn informieren, bei Nichtreaktion Hausverwaltung/Vermieter verständigen und ggf. die Polizei (Notruf 110) bei Gefahr im Verzug rufen.
Der Vermieter muss zwecks Notabdichtung kontakiert werden.
VOCs (Volatile Organic Compounds) sind flüchtige organische Verbindungen. Es handelt sich um Gase oder Dämpfe in die Raumluft.
VOC Werte über 65 Punkte gelten als schlecht.
Hohe Konzentrationen können in Innenräumen zu Beschwerden führen. Dazu zählen Kopfschmerzen sowei Reizungen von Augen, Nase und Rachen. Bei starken Schadstoffbelastungen können zudem Nerven oder Organe beeinträchtigt werden.
"DANN TRAGE ICH DAS HIER REIN"
Die Nachbarn: "Die haben die Adresse"
Die Kartendaten (Name, Anschrift, Geburtsdatum, Geschlecht und Versicherungsnummer) dienen der Identitätsprüfung bei Ärzten und zur Abrechnung mit der Versicherung. Der Arzt gleicht ihre Daten mit einem Programm ab. Das System prüft online ob das Versicherungsverhältnis aktuell ist.
Der Datenschutz wird gewährt, da Basisdaten nur auf dem Chip gespeichert und nicht auf die Karte gedruckt sind. Ohne diese daten könnten Ärzte ihre Leistungen nicht sicher gegenüber der Versicherung geltend machen.
"Sie machen nix"
"DA HAT SICH VIEL ANGESTAUT"
Wenn ein fremder Kunde an der Supermarktkasse die eigenen Artikel anfasst, sprich die Person freundlich an und bitte sie, deine Sachen nicht zu berühren.
Der Kunde: „Die Ware ist auf dem Kassenband verklemmt“
Falls das nicht hilft, informiere das Kassenpersonal, um die Situation zu klaren.
Der Kunde: „Mach Platz“
Der Kunde darf die Ware nicht berühren. Weisen Sie ihn freundlich darauf hin, dass Sie den Platz selbst schaffen.
"MACHEN SIE MAL PAUSE"
Isaac Newton, ein englischer Naturwissenschaftler, entdeckte die unsichtbare Schwerkraft als er einen Apfel von einem Baum fallen sah im Jahr 1665. Er berechnete die Erdbeschleunigung (g = 9,81 m/s²) die ein Körper der Masse (m) im freien Fall auf der Erde erfährt. Die Krafteinheit Kilonewton (1 kN = 100 Kilogramm * 9,81 m/s²) ist nach dem Mathematiker benannt.

Bild vom Sturz: Leonhard Euler, ein Schweizer Mathematiker, berechnete die höchste Druckkraft, bei der eine Stütze wackelt bereits im Jahr 1744, Berlin.
Bild 1 vom skulpturalen Schornstein: Gaudi entwarf das Wohnhaus im Jahr 1906, Barcelona.
Bild 2 vom Stahlbeton-Skelettbau mit einem Flachdach: Walter Adolf Georg Gropius entwarf eine Hochschule für Kunst und Handwerk im Jahr 1925, Dessau.

Eine handgemalte Gemäldekopie nach Wassily Kandinsky, ein russischer Maler. Auf Spitzen, 1928. Reproduktion: 2009, Apuarell auf Leinwand. Abstrakte Kunst gespannt auf Holzrahmen. Limitierte Auflage 99 Exemplare. Format 60 x 60 cm. Bestellnummer 2009MH-001 € 74,-

Bild: "Die können gefährlich werden"

Bild vom Wagen: Ich bin schnell fertig mit dieser Anhängerkupplung.
Bild vom Naturschutzgebiet: Darf ich meine old Schuhe in den See werfen?
"DAS LÖST ER" (LANDSTUHL)
Zahnarzt: "Wissen sie was ich dann mache"
"WIR HABEN NOCH ANDERE PROBLEME"
"DAS WAR DAS PROGRAMM"
Wohnungseinbruch im Arzttermin?
"SIE HAT DEN FEHLER GEMACHT" (OBERARNBACH)
Die möglichen Ursachen für ein undichtes Rohr ist Alterung und Temperaturunterschiede. Heißes Wasser aus der Spülmaschine kann das Tonrohr belasten und zu Spannungsrisse führen. Das kommt vor, dass die brechen und ausgetauscht werden müssen.
Tonrohre halten bei fachgerechter Verlegung oft 100 Jahre und länger. Sie sind für Abwassertemperaturen bis 100 Grad ausgelegt.
"HOL BITLOCKER"
"Werf die in den Müll"
"SIE GEHEN IN DEN MORD. SIE SIND DUMM"
"Die Amerikaner waren drin"
DIE POLIZEI: "ICH BIN KRANK. MACH BLAULICHT AN"
DIE NACHBARN: "DER IST DUMM" (LUISENSTRAßE 40, 66953 PIRMASENS)
Der Kohlenmonoxid Gehalt wird in der Maßeinheit ppm (parts per Million) angegeben. 1000 Kohlenmonoxid Bestandteile auf 1.000.000 Abgasbestandteile (1000 Kohlenmonoxid Teile, 999.000 andere Teile).

Bild von der Gastherme für Warmwasser: Hugo Junkers erfand den Flüssigkeits-Erhitzer im Jahr 1892 in Dessau.
"DER INGENIEUR IST DUMM"
Durch die Verbrennung von Erdgas entsteht Wasserdampf und Kohlendioxid (CO2). Kohlenmonoxid (CO) entsteht, wenn die Verbrennung von Erdgas durch verminderte Sauerstoffversorgung abläuft (Unvollständige Verbrennung).
Schon bei einer Belastung mit Kohlenmonoxid von 80 mg/m³ über einige Stunden hinweg können Luftnot und Brustschmerzen beobachtet werden.
Bei Werten über 500 ppm in einem Gebäude sind die Verbrennungseinrichtungen Falsch eingestellt und eine Wartung der Anlage wird dringend empfohlen.
Die Kohlenmonoxid Grenzwerte für eine raumluftabhängige Gastherme darf nicht mehr als 1000 ppm Kohlenmonoxid (CO) im unverdünnten Abgas enthalten. Über 1000 ppm kann bei Abgasaustritt lebensgefährlich sein und die Anlage muss durch den Schornsteinfeger überprüft werden.
DAS GASLECK

Bild mit dem fehlenden Gaszähler
Dreht sich der Gaszähler weiter, auch wenn der Gasherd und die Gastherme ausgeschaltet ist, ist die Gasleitung undicht.
Die Hanffasern in den Gewindeverbindungen können schrumfpen, wodurch diese undicht werden.
Sobald eine Undichtigkeit gemeldet wird, sind die Stadtwerke verpflichtet die Stahlgasleitung still zu legen, indem sie den Gaszähler ausbaut.
EIN UNDICHTEST GEWINDE
Der Heizungsableser: "Das muss der Vermieter machen"
Belastungen wie starkes Ruckeln können Gewindeverbindungen lockern.
Der Heizungsableser: "Der ist doof"
DIE NACHBARN: "WIR WOLLEN SCHLAFEN"
Vorsätzliche Körperverletzung liegt vor, wenn jemand eine andere Person bewusst und gewollt körperlich misshandelt (Schlag oder üble Behandlung) oder an der Gesundheit schädigt (Steigern eines krankhaften Zustands).
"SIE WERDEN UMDREHEN"
Das Krankenhaus: "Sie röntgen die Lunge"
Die Nachbarn: "Wir dürfen es anstecken"
"WISSEN SIE, WAS DAS FÜR KEIME SIND"
Bild vom Nährboden
Die Kontamination durch Mikroorganismen in die Trinkwasserinstallation nach Straßenreparaturen.
Im Wasser befindet sich auch Organik, dadurch entstehen organische Ablagerungen (Biofilm) im Rohrnetz. In diesem Biofilm (Schleimschicht) vermehren sich Bakterien, die ins Trinkwasser gespült werden.
Biofilm Entfernen
1. Die mechanische Reinigung der sanitären Einrichtungen.
2. Alle Zapfstellen mit heißem Wasser durchströmen. Voraussetzung die Installationsmaterialien sind für die Thermische Desinfektion geeignet.
3. Die Leitungen mit Chemikalien desinfizieren.
"DER WIXXER FLIEGT RAUS"
„Du bist krank“
„Auf die Nerven gehen“
Die Waschmaschine meiner Nachbarn erzeugt beim Schleudern durch hohe Drehzahlen laute Geräusche (z.B. Lagerschaden).
Gegenlärm ist verboten und kann dazu führen, dass Sie selbst eine Kündigung riskieren.
"Die Wohnung ging schief"
"Du kriegst die Anzeige"
„Du kriegst die Kündigung“
Die Nachbarn Scharf/Dörfler: "Die werden krank machen"
Die Nachbarn Scharf/Dörfler laden die Waschmaschine auf den Anhänger.
„Sie waren im Hahnenkorb“
"Das waren die Archlöscher"
"Halt dein Mund"
"Das studiert er“
„Wir haben Herr Weiss angerufen“
Herr Julian Weiss: "Was stimmt da nicht? Ich finde das blöd wenn ich das viermal höre. Die Wand steht schon. Die Firma German kümmert sich um den Keller"
"Die Türken verprügeln dich"
Die Nachbarn Scharf/Dörfler: "Wir waren das"
Die Nachbarn Heimsott: "Zieh aus"

Bild: Der Bauschutthaufen Folge 1

Bild: "Das war schon die Klingel"
"DU KRIEGST KEINE LUFT"
Gluckernde Geräusche im Abfluss sind eine teilweise Rohrverstopfung, aber noch kein Verschluss des Abwasserrohrs.
DIE NACHBARN: "DAS RIECHT WIE GAS"
Es tritt auch ein Kanalgestank auf.
Die Abwasser-Rohrwandungen setzen sich mit der Zeit oft mit Ablagerungen wie Kalk, Urinstein, Seifenresten, Fett, Öl und anderen harten Verkrustungen zu, die den Durchmesser des Rohrs nach und nach verringern.
Das Blubber-Geräusch im Abfluss entsteht durch aufsteigende Luftblasen, die an der Oberfläche der Wassersäule zerplatzen. Letztendlich ist es das gleiche Prinzip, wie wenn Sie eine Wasserflasche auf den Kopf stellen und leeren. Stellen Sie sich eine durch Verstopfung verursachte Engstelle im Rohr vor: Das abfließende Wasser muss sich hindurch quetschen und staut sich davor zu einer Wassersäule, die auf die darunter liegende Luft drückt. Der gestiegene Luftdruck sucht sich einen Weg durch das Wasser eines Siphons, steigt durch ihn blasenförmig nach oben auf und die Luftblase zerplatzt an der Wasseroberfläche. Das dabei charakteristische „Blubb“ ist im Abfluss hörbar.
DIE NACHBARN: "DU MACHST DAS ROHR KAPUTT"
Reinigen Sie das alte Rohr am besten nicht mit einer Rohrreinigungsspirale.
DIE POLIZEI: "DAS IST RECHTS"
DER INSTALATEUR VON ROSA: "WIR MACHEN DAS NICHT. DIE LUFT BRENNT"
Haben Sie mit Durchspülen von Wasser keinen Erfolg, ist es notwendig, den Geruchsverschluss anzupassen oder einen Rohrreinigungsdienst zu bestellen.
Bild: Das gluggernde Badewannensiphon.
Bild 1: Die Nachbarn: "Die Nachbarin war in der Klappe"
Bild 2: "Haben sie da was eingebaut"
"DER MACHT DEINE HEIZUNG KAPUTT"
Sind Geräusche aus der Heizungsanlage selbst (blubbern, hämmern) zu hören, liegt ein technischer Defekt vor und es handelt sich um einen Mietmangel.
Dauerhaftes Klopfen gegen die Heizung gilt als Lärmbelästigung, wenn es als Mittel gegen Lärm dient. Ständiges Klopfen gegen Wand oder Decke, um sich über Nachbarn zu beschweren, ist keine Notwehr.
Wer dies tut, riskiert Abmahnungen oder kann zu Schmerzensgeld verpflichtet werden.
"HOL HANDWERKER"
"DAS WAR GAS"
Die Nachbarn Scharf/Dörfler: "Was machen sie da? Pass auf"
Ich sitze am Schreibtisch und es riecht nach Erdgas.
Die Polizei: "Machen Sie mal aus"
"DAS WAR DIE PUMPE"
Bild: Der Keller

Bild: Die Wasserpumpe mit Funktechnologie

Bild: Der Bauschutthaufen Folge 2
Vermieterin, Frau Iris Klinck Weiss, Am Sportplatz 6, 66987 Thaleischweiler: "Ich will meine Ruhe haben"
"SIE SEHEN DEN RING"

Bild vom Hotel Iberostar Creta Marine auf Kreta
Dichtringe verhindern den Austritt von Gasen und Flüssigkeiten. Kanalisationsgeruch im Hotelzimmer entsteht durch Fehlen der Dichtung zum Geruchsverschluss.
In Griechenland gilt das Recht der Europäischen Union. Beschweren und reparieren lassen, erforderlichenfalls anderes Zimmer verlangen.
"ICH HABE SPORT GEMACHT"
Sonographie - Eine Schulterprellung durch einen Schlag auf das Autolenkrad.
"DER IST KRANK"
Ich ging in die Bar und als ich betrunken war, kam Herr Matthias Bodendorfer, Am Moorteich 35, 31812 Bad Pyrmont auf mich zu und schlug mir an das Kinn, drückte mich am Hals mit seinem Unterarm gegen die Wand. Er sagte zu mir: „Lass die Frau zufrieden. Ich bin mit der Frau befreundet.“ Vor dem Ausgang der Bar stand er vor mir. Er sagte: „Los, komm.“ Der Matthias ging vor mir auf den Gehweg an den Gästen vorbei, blieb stehen und drehte sich um. Er bückte sich und umgriff meinen Bauch. Ich nahm ihn in den Würgegriff. Er löste den Griff an meinen Daumen und stellte mir ein Bein. Ich fiel zu Boden.

Bild: "Der hat Ihnen den Daum umgedreht"
FRAU WEBER. "ICH MUSS NOCH IN DIE FIRMA"

Bild: Die höhenverstellbaren Bürostuhl Armlehnen.
Nackenschmerzen nach falsch eingestellten Bürostuhl Armlehnen.
Chef, Herr Dirk Weber, Hochstraße 39, 66894 Bechhofen: "Holen Sie mal Luft. Das hätten Sie nicht machen sollen. Hätte ich den mal nicht eingestellt"
"Der ist im Urlaub"
"Mach ein Loch rein"
"Er soll drauf gehen"
"Dann wäre die Tür zu gewesen"
DIE ÄRZTE
"Nehmen Sie die Tabletten. Dann muss ich zu meinen Mann gehen"
"Mein Mann hat mir die gegeben"
Dr. med. Joachim Scholl Facharzt für Orthopädie: "Sie ziehen ja immer die Schultern hoch"
Schulter Gelenke Knacken nach einrenken von Dr. med. Joachim Scholl.
Wiederholter Fernsehfilm Edge of Tomorrow: Schulterknacken nach Liegestützen am Morgen.
Dr. med. Joachim Scholl: "Dann machen wir da nichts mehr"
"ICH DENKE, DAS IST EIN PSYCHISCHES PROBLEM"
Die Staatsanwaltschaft: Das Verfahren wird eingestellt, weil Verjährung eingetreten ist. Eine Privatklage ist nicht mehr möglich, da die Tat strafrechtlich nicht mehr verfolgt werden kann.
"DAS IST GUT"

Bild: Ich Erbreche die Krankheitserreger ins Essen.
Arzt, Christian Gimenez verschreibt Loperamid Tabletten was den Stuhldrang vermindert und die Keime bleiben im Körper drin.
Apothekerin: "Sie waschen ab."
Antibiotiker sind Tabletten die Bakterien abtöten oder deren Wachstum hemmen.
Kopfschmerzen sind eine Nebenwirkung von Antibiotika.
DER INSTALLATEUR KOMMT (ANNENSTRAßE 11, 31812 BAD PYRMONT)

Bild vom Heizkörperthermostat: Der Installateur, Rüdiger Barchfeld, Schäfergasse 2, 31812 Bad Pyrmont montiert ein defektes Heizungsventil.
Ein defektes Heizkörperventil, das sich nicht mehr schließen lässt, führt zu einem dauerhaften Durchfluss von heißem Wasser, wodurch der Heizkörper auch bei zugedrehtem Thermostat weiterheizt. Dies verursacht höhere Heizkosten.
Rüdiger Barchfeld: "Dann gibt es Ärger mit der Rechnung"

Bild vom Küchensiphon
Gluckernder Badewannensiphon nach Vor-Ort-Termin vom Installateur Rüdiger Barchfeld. Das Abflussrohr ist durch Topfreiniger verstopft. Wenn ein Abflussrohr keine Entlüftung über Dach besitzt, wird der gluckender Badewannensiphon (Geruchsverschluss) leergesaugt und die Kanalgase breiten sich in der Wohnung aus.
Installateur, Rüdiger Barchfeld: "Sie waren ja gar nicht beim Arzt"
Der Installateur Mitarbeiter: "Zieh aus"
"ES IST OFFEN. HAST DU DIE SCHLÜSSEL. JETZT NICHT MEHR"
Wenn der Installateur Mitarbeiter die Schlüssel für den Heizungsraum nicht zurückgibt, handelt es sich um eine Unterschlagung.
Der Vermieter besitzt das Hausrecht und muss keinen ständigen Zugang zum Heizungsraum gewähren, solange die Heizung funktioniert und die Temperaturen in der Wohnung stimmt.
Wenn Sie die Heizung nicht selbst regulieren können muss der Vermieter ein Notfallzugang gewährleisten. Wenn der Zutritt verweigert wird, kann die Polizei eingeschaltet werden.
Die Polizei: "Idiot"
Die Polizei: "Du gehst da nochmal rein"
Installateur, Rüdiger Barchfeld: "Sie dürfen das nicht"
Die Polizei: "Sie können es doch in den Briefkasten stecken"
Frau Barchfeld: "Warum ziehen Sie nicht einfach aus"
"Weiss ist der Idiot"
"DAS WAR DAS WASSER"

Bild: Das war das braune Leitungswasser.

Bild: "Wir verprügeln in gut"
Bild: Das waren die Pilze im Leitungswasser.
Bild: Das waren die Bakterien im Leitungswasser.

Bild vom Nährboden: Das waren die Keime im Leitungswasser.
"DER MACHT DEINE BIRNE KAPUTT"

Bild vom Warmwasserspeicher: "Er ist nicht ganz sauber"
Rost, Kalk, Sand und Lehm sammeln sich im Warmwasserspeicher, bilden einen Nährboden für Mikroorganismen, weshalb eine regelmäßige Reinigung empfohlen wird.
Die Temperaturen im Speicher sollten über 60 Grad Celsius liegen (mindestens 55 °C am Wasserhahn), um Keimvermehrung zu verhindern.
DER STURZ

Bild vom gemauerten, scheitrechten Fensterbogen: Die Kalksandersteine.














